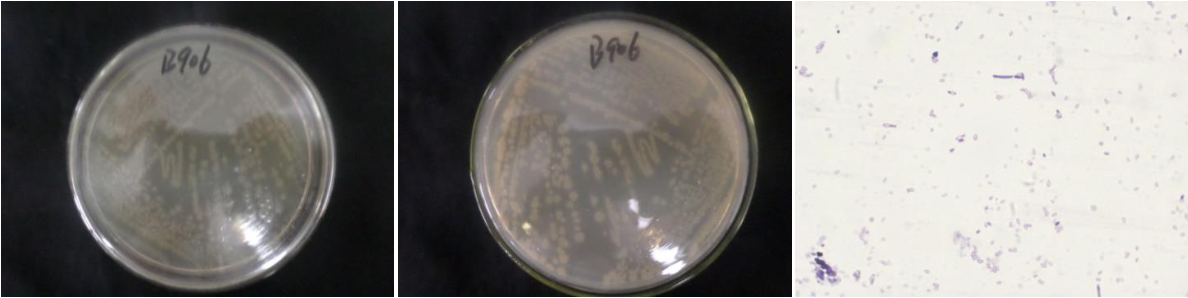

Loading...
| StrainNO | B906 |
| Classification | Bacillus |
| 16s rDNA sequence | TACATGCAAGTCGAGCGGACTTAAAAAGCTTGCTTTTTAAGTTAGCGGCGGACGGGTGAGTAACACGTGGGCAACCTGCCTGTA AGACTGGGATAACTTCGGGAAACCGGAGCTAATACCGGATAATCCTTTTCTACTCATGTAGAAAAGCTGAAAGACGGTTTACGC TGTCACTTACAGATGGGCCCGCGGCGCATTAGCTAGTTGGTGAGGTAACGGCTCACCAAGGCGACGATGCGTAGCCGACCTGAG AGGGTGATCGGCCACACTGGGACTGAGACACGGCCCAGACTCCTACGGGAGGCAGCAGTAGGGAATCTTCCGCAATGGACGAAA GTCTGACGGAGCAACGCCGCGTGAGTGATGAAGGTTTTCGGATCGTAAAACTCTGTTGTTAGGGAAGAACAAGTACGAGAGTAA CTGCTCGTGCCTTGACGGTACCTAACCAGAAAGCCACGGCTAACTACGTGCCAGCAGCCGCGGTAATACGTAGGTGGCAAGCGT TGTCCGGAATTATTGGGCGTAAAGCGCGCGCAGGCGGTCCTTTAAGTCTGATGTGAAAGCCCACGGCTCAACCGTGGAGGGTCA TTGGAAACTGGGGGACTTGAGTGCAGAAGAGAAGAGTGGAATTCCACGTGTAGCGGTGAAATGCGTAGAGATGTGGAGGAACAC CAGTGGCGAAGGCGACTCTTTGGTCTGTAACTGACGCTGAGGCGCGAAAGCGTGGGGAGCAAACAGGATTAGATACCCTGGTAG TCCACGCCGTAAACGATGAGTGCTAAGTGTTAGAGGGTTTCCGCCCTTTAGTGCTGCAGCAAACGCATTAAGCACTCCGCCTGG GGAGTACGGCCGCAAGGCTGAAACTCAAAGGAATTGACGGGGGCCCGCACAAGCGGTGGAGCATGTGGTTTAATTCGAAGCAAC GCGAAGAACCTTACCAGGTCTTGACATCTCCTGACAATCCTAGAGATAGGACGTTCCCCTTCGGGGGACAGGATGACAGGTGGT GCATGGTTGTCGTCAGCTCGTGTCGTGAGATGTTGGGTTAAGTCCCGCAACGAGCGCAACCCTTGATCTTAGTTGCCAGCATTT AGTTGGGCACTCTAAGGTGACTGCCGGTGACAAACCGGAGGAAGGTGGGGATGACGTCAAATCATCATGCCCCTTATGACCTGG GCTACACACGTGCTACAATGGATGGTACAAAGGGCAGCAAAACCGCGAGGTCGAGCCAATCCCATAAAACCATTCTCAGTTCGG ATTGTAGGCTGCAACTCGCCTACATGAAGCTGGAATCGCTAGTAATCGCGGATCAGCATGCCGCGGTGAATACGTTCCCGGGCC TTGTACACACCGCCCGTCACACCACGAGAGTTTGTAACACCCGAAGTCGGTGGGGTAACCTTTTAGGAGCCA |
| Strain Morphology Photos | |
| Morphological Description | The morphology of Colony round;clam white;edge serrated;flat;concentric ring;more wrinkles;slippy;sticky;waxy;The morphology of strain:Rod;having spore;bias in spores |